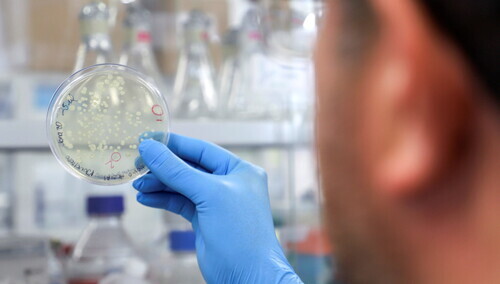

Prof. Gut: Samoeliminacja koronawirusa nie nastąpi, będzie on z nami obecny
Wciąż pojawiają się nowe warianty koronawirusa. Public Health England poinformował przed kilkoma dniami o wykryciu w Wielkiej Brytanii 16 przypadków zakażenia nowym, nieznanym dotąd wariantem koronawirusa SARS-CoV-2. Na razie wiadomo tylko, że zawiera on tę samą mutację E384K, co rozprzestrzeniające się na świecie warianty z RPA i Brazylii.
Wirusolog z Warszawy prof. Włodzimierz Gut zauważa, że do samoeliminacji koronawirusa raczej nie dojdzie, ponieważ każda populacja tego wirusa składa się z wielu mutacji. W różnych zatem wariantach będzie on z nami obecny.
"Ten wirus to 'mieszanina' mutacji. W trakcie jego namnażania to nie jest duplikacja, jak w innych organizmach, lecz przepisywanie na jednej tzw. matrycy całej serii cząsteczek, z częstością błędów jeden na tysiąc nukleotydów. W związku z tym tworzy się taka populacja cząsteczek zawierająca tysiące błędów. Część z nich jest eliminowana przez właściwości kodu genetycznego, a część przestaje być aktywna, bo nie jest w stanie się namnażać, są to tzw. cząstki defektywne. Reszta szuka następnych komórek i w każdej komórce ten proces się powtarza" - wyjaśnia.
Jeden wariant koronawirusa, np. wariant brytyjski, zaczyna dominować, a w przypadku pozostałych tych drobnoustrojów przerywane są drogi ich szerzenia się. "Jeżeli jakiś patogen powoduje zmiany w obrazie choroby, to też zaczyna być dominujący albo jest eliminowany. Bo taki wariant nie musi zaraz dominować, może być zastępowany przez kolejne" - dodaje specjalista.
Zwraca uwagę, że powstawania nowych koronawirusów nie można porównać do zmian, jakim podlega wirus grypy. Jest to - tłumaczy - wirus segmentowany, czyli jego genom jest w kawałkach i one się mieszają. W przypadku koronawirusa mutacje powstają w naturalny sposób w procesie jego replikacji.
W efekcie cały czas powstają nowe warianty tego patogenu. "Jedynie wariant, który będzie miał uszkodzoną zdolność rozpoznania ludzkich komórek, przestanie istnieć. Można powiedzieć, że sam się wyeliminuje, na skutek tzw. zmian zakazanych" - stwierdza prof. Gut. Będą jednak inne warianty SARS-CoV-2.
Badania genomu wykrywanych koronawiorusów u osób, które się nimi zakaziły, pokazują jak mutują i skąd pochodzą. Roznoszone są po całym świecie wraz przemieszczaniem się ludności. Na przykład wariant nigeryjski trafił do Anglii, ponieważ są między tymi krajami dość częste kontakty ludności. Z kolei brytyjski wariant mógł zostać zawleczony do Polski, kiedy na święta Bożego Narodzenia przyjechali do kraju rodacy z Wysp.
"Pocieszające jest, że szczepionka - indukując odporność na jedno białko koronawirusa - zabezpiecza przed nim. Może się to zmieniać w procentach, w jedną lub drugą stronę, ale będzie zabezpieczała przed różnymi wariantami tego patogenu" - zapewnia specjalista.
Jego zdaniem nie musi koniecznie powstać szczepionka uniwersalna. Wystarcza taka, jaka jest obecnie wykorzystywana, oparta o białko receptorowe (białko kolca). "Te szczepionki powinny chronić przed różnymi wariantami, bo indukują odpowiedź dla tego obszaru. Byle tylko szczepienia postępowały jak najszybciej, ale na razie nie chcą" - podkreśla.
O tym, jak dobre efekty dają stosowane obecnie szczepienia, pokazuje przykład Izraela, gdzie zaszczepiono ponad połowę populacji. "Mieli oni dostęp do szczepionki, bo zarazem była to weryfikacja zdolności szczepionek do uodpornienia już na masową skalę. Badania kliniczne trzeciej fazy obejmują 30-40 tys. osób, a tu mamy kilka milionów" - zwraca uwagę prof. Gut.
Przekonuje, że poszczególne warianty koronawirusa rzadko występują jednocześnie, dlatego mało prawdopodobne jest, by ta sama osoba została zakażona jednocześnie wariantem brytyjskim i brazylijskim lub południowoafrykańskim. "U danego osobnika zakaża zawsze jeden z koronawirusów - i nie ma większego znaczenia, jaki on jest. Przebieg zakażenia i choroby jest podobny, może być jedynie z innym nasileniem. Niebezpieczeństwo byłoby dopiero wtedy, gdyby poszczególne warianty wywoływały inne choroby" - zaznacza prof. Włodzimierz Gut.
Zbigniew Wojtasiński
zbw/ zan/
Komentarze
Wiceminister zdrowia: „Powinniśmy traktować COVID-19 (…) jak na przykład wirusa grypy”

Joe Biden ma koronawirusa. Jego osobisty lekarz wydał komunikat
Trzaskowski znowu z koronawirusem. Oskarżenia w kierunku PiS
60-procentowy wzrost zakażeń koronawirusem. Niedzielski ogłosił ważną decyzję




